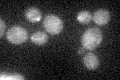

View description
Phosphorylated protein of the mitochondrial outer membrane, localizes only to mitochondria of the bud; interacts with Myo2p to mediate mitochondrial distribution to buds; mRNA is targeted to the bud via the transport system involving She2p
Localization:
Intensity:
Fold change:
Significance:
-
C’ GFP library in SD
punctate:cytosol27.59 -
N' NOP1pr-GFP in SD

N/A0 -
N' TEF2pr-mCherry in SD

N/A0 -
N' NATIVEpr-GFP in SD

N/A0 -
N' TEF2pr-VC and Cyto-VN in SD

N/A0 -
C’ GFP library in SD+DTT

punctate.cytosol26.80.97No -
C’ GFP library in SD+H2O2

punctate.cytosol22.940.83No -
C’ GFP library in Starvation Media

punctate,cytosol17.810.64Yes -
C’ GFP library on the background of Pup2-DaMP

punctate:cytosol -
C’ GFP library on the background of CCT mutant

punctate:cytosol26.56820.962676No
